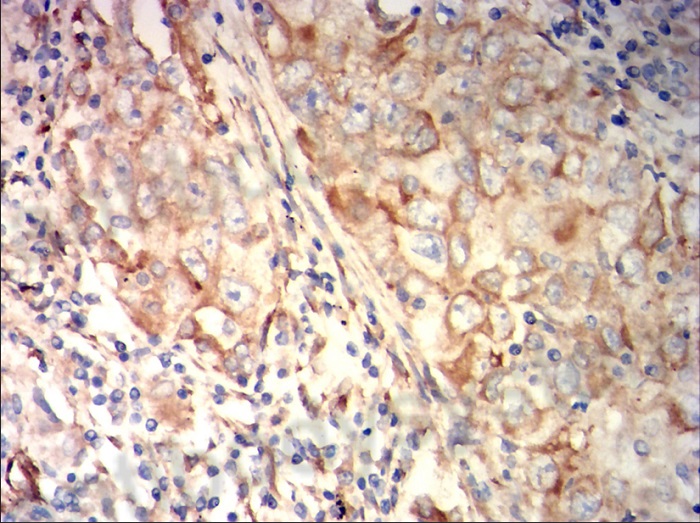
5 - 副本.jpg 5 - 副本.jpg

3YR企业会员
发布人:武汉佰乐博生物技术有限公司
发布日期:2025/12/3 14:38:55
纤维蛋白原是由肝细胞合成的一种高分子量糖蛋白,是凝血系统中的关键因子,同时也是一种重要的急性时相反应蛋白。它由两对α链、β链和γ链组成,总分子量约340 kDa。纤维蛋白原在凝血酶作用下可转化为纤维蛋白,参与止血和血栓形成过程。在炎症反应中,纤维蛋白原水平显著升高,是评估机体炎症状态的重要指标之一。
其结构可分为:
(1)中央E区与两端D区:由α、β、γ链通过二硫键连接形成对称结构,是纤维蛋白聚合和交联的关键区域;
(2)凝血酶切割位点:位于α链与β链的特定区域,凝血酶作用后释放纤维蛋白肽A和B,启动纤维蛋白聚合;
(3)细胞结合位点:γ链上含有与血小板整合素αIIbβ3结合的RGD序列,参与血小板聚集和炎症细胞黏附。
在炎症状态下,纤维蛋白原不仅作为凝血因子参与修复,也通过结合白细胞、调节炎症介质释放等方式,直接参与炎症反应的调控。

Schematic Representation of Fibrinogen Polypeptide Chains
(Int J Mol Sci. 2025 Feb 5;26(3):1336.)
纤维蛋白原的临床应用
纤维蛋白原与心血管疾病
纤维蛋白原水平升高是动脉粥样硬化和血栓形成的独立危险因素。研究表明,血浆纤维蛋白原浓度与冠心病、心肌梗死、脑卒中的发生风险呈正相关。其机制可能涉及促进血小板聚集、增强血液黏稠度、参与血管壁炎症反应等。定期监测纤维蛋白原水平,有助于评估心血管事件风险并指导抗凝或降纤治疗。

Thrombus formation
(Int J Mol Sci. 2025 Feb 5;26(3):1336.)
纤维蛋白原与炎症性及感染性疾病
在感染、创伤、手术等应激状态下,纤维蛋白原作为急性期蛋白迅速上升。其升高程度与炎症严重程度相关,可用于评估全身性炎症反应综合征(SIRS)、脓毒症等疾病的严重程度及预后。此外,纤维蛋白原在类风湿关节炎、系统性红斑狼疮等自身免疫性疾病中也常升高,反映疾病活动性。
纤维蛋白原与肿瘤
多种恶性肿瘤患者血浆纤维蛋白原水平升高,可能与肿瘤相关炎症、凝血激活及肿瘤细胞自身分泌有关。高纤维蛋白原血症与肿瘤进展、转移及不良预后相关,可作为肿瘤辅助诊断及预后评估的参考指标。
纤维蛋白原与妊娠及产科疾病
妊娠期纤维蛋白原生理性升高,以适应分娩时的止血需求。但异常升高可能与子痫前期、胎盘早剥等产科并发症相关,需结合临床综合评估。
纤维蛋白原作为一种多功能蛋白,在凝血与炎症交叉网络中发挥重要作用。其检测简便、成本低,已广泛应用于临床炎症、血栓及肿瘤相关疾病的辅助诊断与监测。未来,其在个性化抗凝治疗及炎症靶向治疗中的应用前景值得进一步探索。
AntibodySystem提供高纯度、高活性的纤维蛋白原蛋白及相关抗体,适用于凝血功能检测、炎症标志物分析及体外诊断试剂开发。
货号
产品名称
YHB99202
Recombinant Human FGB/Fibrinogen beta Protein, N-His
YHB99201
Recombinant Human FGB Protein, N-His
YHG77601
Recombinant Human FGL2 Protein, N-His
YHB99102
Recombinant Human FGA Protein, N-His
PHA16901
Anti-FCN1 Polyclonal Antibody
PHG77602
Anti-Human FGL2 Polyclonal Antibody
RHB99101
Anti-FGA Antibody (R1H98)
RHB99302
Anti-FGG Antibody (R2X99)
Anti-Human FGL1/HFREP1 Monoclonal Antibody (1A491) [MHG17901]

Black line: Control Antigen (100 ng);Purple line: Antigen (10ng); Blue line: Antigen (50 ng); Red line: Antigen (100 ng)

Immunofluorescence analysis of Hela cells using FGL1 mouse mAb (green). Blue: DRAQ5 fluorescent DNA dye. Red: Actin filaments have been labeled with Alexa Fluor- 555 phalloidin.
Immunohistochemical analysis of paraffin-embedded lung cancer tissues stained for FGL1/HFREP1 with MHG17901.
Anti-FGG Antibody (R2X99) [RHB99302]

Immunofluorescence analysis of NIH/3T3 cells using FGG mouse mAb (green). Blue: DRAQ5 fluorescent DNA dye. Red: Actin filaments have been labeled with Alexa Fluor-555 phalloidin.
更多纤维蛋白原(Fibrinogen)产品请点击:https://www.antibodysystem.com/index/search?wd=Calprotectin
佰乐博生物作为AntibodySystem亚洲独家代理,将为您的科研工作提供专业、全面、可靠的试剂产品。更多产品详情欢迎致电或者添加产品专员微信咨询!

扫码添加产品专员微信
电话:027-65279366
相关新闻资讯